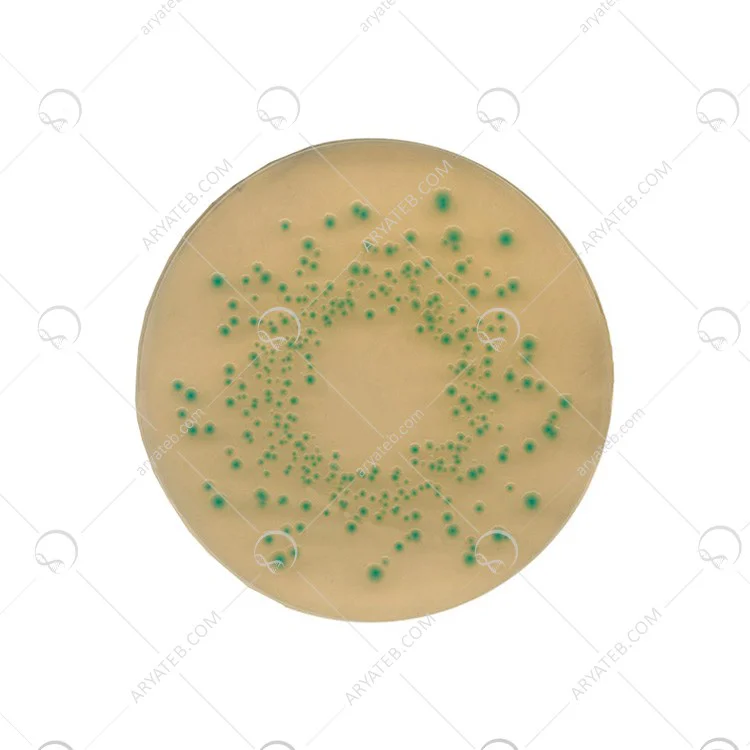

تریپتون بایل آگار tryptone bile agar
محیط کشت تریپتون بایل آگار tryptone bile agar
با گذشت هایی که در گذشته عامل مرگ گروه زیادی از انسان ها یا حیوانات بوده است، کنترل شده یا از بین رفته است. در زمان تعدادی از بیماری کنار آن، بیماری ها و اختلالات جدیدی ظاهر شده است که عامل برخی از آن ها هم چنان ناشناخته مانده است.
بنابراین محققان هر روزه به دنبال بررسی و شناسایی انواع میکروارگانیسم ها هستند. یکی از راه های شناسایی و بررسی آن ها استفاده از محیط کشت است. به این شکل آن ها می توانند میکرو ارگانیسم مورد نظر را کشت داده و با ویژگی های اساسی آن ها آشنا شوند. نتیجه این بررسی ها کنترل بیماری ها یا کاهش انتشار آن ها در میان موجودات زنده است.
بررسی نحوه بیماری زایی، تنها دلیل نیاز به محیط کشت برای تحقیقات نیست. در میان این موجودات میکروسکوپی، گروه های غیربیماری زا مانند باکتری های مفید بدن انسان نیز یافت می شود. حضور این دسته از موجودات نه تنها برای دیگران مضر نیست، بلکه برای انجام برخی فرایند ها ضروری نیز می باشند. بهتر است قبل از هر چیز با محیط کشت و ویژگی های آن آشنا شویم.
محیط کشت چیست؟
محیط کشت در واقع یک محیط مایع یا نیمه جامد است. از این محیط برای رشد میکروب ها، گیاهان کوچک و مواردی از این قبیل استفاده می شود. این محصول در آزمایشگاه ها برای بررسی سلامت مواد غذایی به کار میروند. علاوه بر این یکی از رایج ترین کاربرد های محیط کشت برای انجام امور تحقیقاتی بر روی انواع میکروارگانیسم ها است.
محیط های کشت در چه طبقه بندی هایی در دسترس هستند؟
محیط کشت ها با توجه به کاربردشان در انواع مختلفی دردسترس هستند. در زیر تعدادی از این محیط ها و کاربرد آن ها را بیان می کنیم. در تمام محیط های کشت زیر شرایطی فراهم می شود که رشد هر موجودی غیر از موجود مورد نظر را مهار کند.
- محیط کشت مغذی : برای رشد انواع باکتری های بیماری زا و غیر بیماری زا
- محیط کشت انتخابی : برای بررسی نوع خاصی از میکروب ها
- محیط کشت تمایزی : به منظور شناسایی و تمایز دو یا چند میکروب از هم
- محیط کشت ترابری : به منظور حفظ و نگه داری از نمونه و جا به جایی آن ها
- محیط کشت غنی شده : با هدف رشد و کشت انواع مختلفی از موجودات زنده
محیط کشت مغذی شامل مواد معدنی، آمینواسید ها، نمک ها، آب و مواردی از این قبیل می باشند. این مواد برای رشد باکتری ضروری هستند. علاوه بر این، در محیط کشت غنی از گلوکز به عنوان منبع انرژی نیز استفاده می شود.
یکی از باکتری هایی که امروزه بسیار مورد توجه محققان واقع شده است، باکتری اشرشیا کلی است. محیط کشت مورد استفاده برای بررسی باکتری اشرشیا کلی، محیط کشت Tryptone Bile Agar است. در ادامه با این باکتری و ویژگی های آن اشنا می شویم. سپس به سراغ محیط کشت متبط با آن می رویم و نحوه استفاده از آن را به شما معرفی می کنیم.
باکتری اشریشیا کلی چیست؟
اشرشیا کلی یا Ecoli گروهی از انتروباکتر ها هستند. این دسته از باسیل ها گرم منفی هستند. این باکتری در دو نوع بیماری زا و غیر بیماری زا وجود دارد. نوع بیماری زا آن عامل ایجاد مسمومیت های غذایی در افراد و در نتیجه آن اسهال، استفراغ ،درد معده، حالت تهوع و سایر علائم مرتبط با مسمومیت است. این سویه های اشریشیا کلی در روده موجودات زنده یافت می شوند.
سویه های بی آزار و غیر بیماری زا اشرشیا کلی در روده، در مقابل سایر باکتری های بیماری زا موجود در آن مقاومت می کنند. این دسته از باکتری ها هم چنین به تولید ویتامین K در روده انسان کمک می کنند. دسته دیگر باکتری های اشرشیا کلی در مجاری ادراری یافت می شوند و عامل عفونت های ناحیه تناسلی خصوصا در زنان هستند. انتقال این باکتری از فردی به فرد دیگر از راه انتقال مدفوعی و دهانی است.
این باکتری ها در اصل فلور طبیعی در روده ها هستند. اما دسته بیماری زا آن ها در سیستم گوارشی انسان ها و حیوان ها باعث بروز اختلال می شوند. انتروتوکسین ها، انتروپاتوژن ها، هموراژیک نمونه هایی از باکتری های بیماری زا اشریشیا کلی هستند.
محیط کشت Tryptone Bile Agar چیست؟
محیط کشت Tryptone Bile Agar یا TBA اولین بار بر اساس فرمول کشف شده توسط اندرسون و پارکر توسعه یافت. این محیط کشت برای شناسایی اشرشیا کلی موجود در مواد غذایی و شمارش آن ها به کار می رود. محیط کشت TBA حاوی نمک، تریپتون، آگار وآب مقطر است. از جمله فواید استفاده از این محیط کشت به تغییر پذیری کمتر، تشخیص سویه های بی هوازی و ضعیف تر، دریافت سریعتر نتیجه و ارائه ریکاوری بهتری از نمونه های فریز شده می توان اشاره کرد.
محیط کشت Tryptone Bile Agar چه ویژگی هایی دارد؟
محیط کشت تریپتون بایل آگار در جهت تشخیص سریع اشرشیا کلی های موجود در آب و غذا به کار می رود. این محیط کشت بر اساس فیلتراسیون غشایی عمل می کند و شامل ویتامین ها، اسید های آمینه، مواد معدنی و نیتروژن مورد نیاز برای رشد و کشت اشریشیا کلی را فراهم می کند. باکتری ها در این محیط از طریق سلولز در دمای 44 درجه سانتی گراد رشد می کنند.
سیستم عملکرد این محیط کشت به صورتی است که سایر میکروارگانیسم ها غیر از اشریشیا کلی را از بین می برد. یکی از مواد غذایی که به کمک این روش و فقط با بررسی میزان کمی از نمونه مورد بررسی قرار می گیرد، گوشت است. مدت زمان لازم برای دستیابی به نتیجه کشت، 18 تا 24 ساعت است.
در استفاده از محیط کشت Tryptone Bile Agar باید به چه نکاتی توجه نمود؟
یکی از نکاتی که در استفاده از محیط کشت باید در نظر داشته باشید، مطالعه دقیق برچسب روی محصول است. علاوه بر این در حین استفاده بهتر است از دستکش، لباس محافظ و همین طور محافظ هایی برای چشم و صورت خود استفاده کنید. به طور کلی باید در استفاده از نمونه ها کلیه نکات ایمنی و بهداشتی را رعایت کنید تا از انتشار میکروب و بیماری جلوگیری شود. توصیه می کنیم قبل از استفاده از محصول حتما برچسب روی محصول و دستورالعمل های ضروری را مطالعه کنید.
آدرس ایمیل شما منتشر نخواهد شد. فیلدهای الزامی علامت گذاری شده اند *